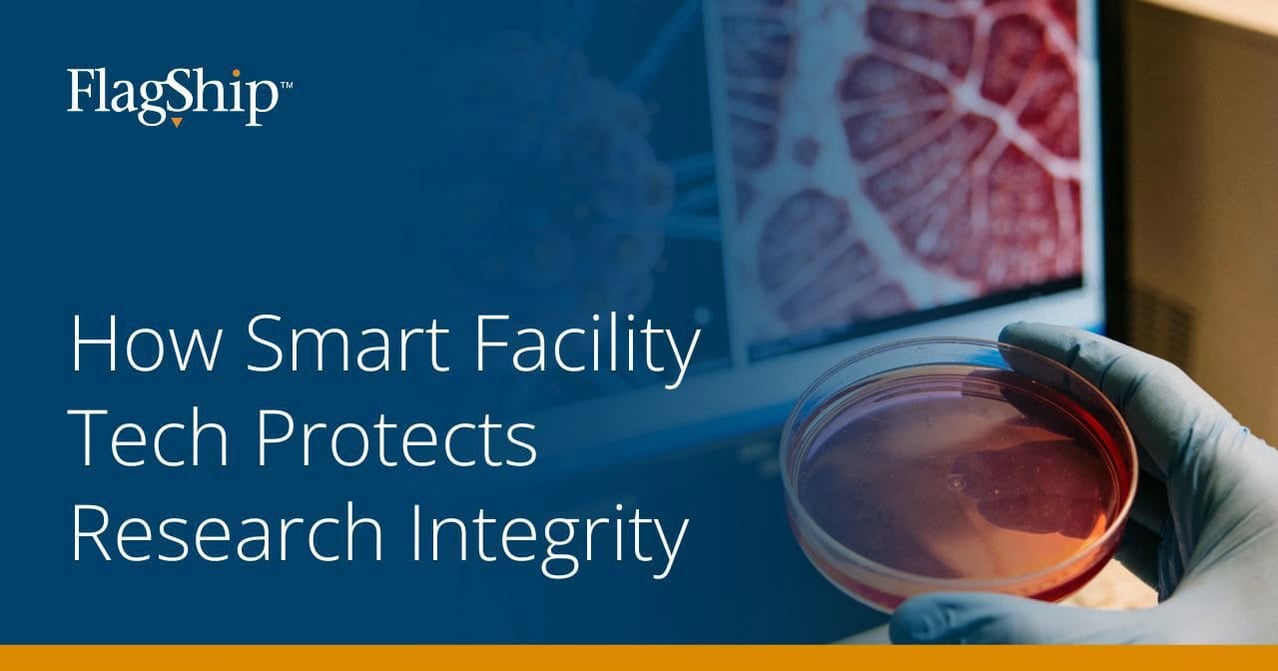
How Smart Facility Tech Protects Research Integrity

Research Integrity Depends on More Than Science
Breakthroughs in Life Sciences don’t happen in isolation. They happen in environments designed for control, consistency, and reliability. From R&D labs to GMP manufacturing spaces, a facility's performance directly influences the validity of data, reproducibility of results, and speed of innovation.
Yet many organizations still rely on manual checks and reactive maintenance strategies in highly sensitive research environments. Smart facility technology is redefining that approach, transforming buildings into intelligent systems that actively protect research integrity. By turning operational data into actionable insight, Life Sciences organizations can reduce risk, strengthen compliance, and enable discovery at scale.
The Role of the Built Environment in Research Integrity
Research integrity in Life Sciences isn’t determined solely at the bench. It’s shaped by the built environment that surrounds it. The facility systems that control temperature, humidity, airflow, pressure, vibration, and power stability create the conditions required for reliable, repeatable science.
When those conditions fluctuate, the impact can be immediate and costly: samples can degrade, reactions can shift, cleanrooms can fall out of specification, containment can weaken, and sensitive instruments can produce inconsistent results. In regulated environments, the built environment carries additional weight. FDA guidance, ISO
standards, and GMP/GLP frameworks require controlled conditions and clear evidence that those conditions were maintained, including documented responses to deviations.
Relying on manual checks and reactive maintenance leaves unavoidable gaps between inspections, where drift can occur without timely intervention or complete documentation. As labs and manufacturing spaces grow more complex, protecting research integrity increasingly requires continuous oversight of the built environment.
Smart Facility Technology in Life Sciences
Smart facility technology is an integrated, data-driven approach to monitoring and managing building performance in real time. In Life Sciences environments, where stability, documentation, and rapid response matter, it helps maintain the conditions research depends on.
Smart facility ecosystems typically include:
-
Building Management Systems (BMS): Controls HVAC, pressurization, and utilities that influence lab conditions
-
Environmental monitoring sensors: Tracks temperature, humidity, differential pressure, air quality, and other critical parameters
-
IoT-enabled devices and equipment telemetry: Captures performance data from infrastructure and lab-adjacent equipment
-
Automated alerts and workflows: Notifies teams immediately when conditions drift outside defined ranges and routes response actions
-
Analytics and reporting dashboards: Turns trends and events into actionable insights and audit-ready records
This connected, real-time oversight creates a more controlled environment, supporting research integrity, operational resilience, and regulatory readiness.
Real-Time Monitoring
Real-time monitoring turns the facility into an active safeguard for research, constantly watching the conditions that experiments rely on. Instead of relying on periodic checks, continuous monitoring provides immediate visibility into the variables most likely to impact data integrity, including:
- Temperature & humidity: Keep samples stable and processes consistent
- Differential pressure: Maintain cleanroom integrity and proper containment
- Air changes per hour (ACH): Sustain airflow performance and reduce contamination risk
- Air quality & CO₂: Protect environmental conditions and support occupant safety
- Equipment status: Confirm critical systems are running and flag issues early
When monitored in real time, deviations trigger automated alerts that allow teams to respond before results are compromised. This shifts facilities from discovering problems after data is lost to preventing failures in the moment, protecting experiments, timelines, and research confidence.
Data Integrity and Auditing
Data integrity in Life Sciences goes beyond experimental results to include the documented conditions under which the work was performed. To meet compliance expectations, facilities need to demonstrate that environmental parameters stayed within defined ranges and that any deviations were identified, addressed, and recorded appropriately.
Smart facility technology automatically captures and stores operational data, creating a digital audit trail that includes:
- Time-stamped environmental readings
- Alarm notifications and response actions
- Maintenance activities and corrective actions
- System performance trends
With this level of documentation built in, teams can reduce manual recordkeeping, limit human error, and streamline audits. Rather than piecing together paper logs and spreadsheets, facilities can quickly generate validated reports that clearly demonstrate control and compliance.
Turning Facility Data Into Strategic Advantage
Beyond day-to-day operations, facility data can become a powerful planning tool. Analytics from smart facility systems help Life Sciences organizations pinpoint efficiency opportunities, such as energy waste, HVAC optimization, and sustainability improvements, without compromising environmental control. They also provide a clearer picture of how lab and support spaces are actually being used, which supports better decisions around scheduling, renovations, and future buildouts.
Over time, these insights strengthen equipment lifecycle planning as well. Instead of relying on fixed schedules or reacting to failures, teams can use performance trends to prioritize maintenance, plan replacements, and budget more accurately. And as research portfolios expand, the same data helps leaders scale operations with confidence, anticipating capacity needs, reducing operational risk, and maintaining consistency across new spaces. Ultimately, smart facility technology turns operational data into strategic intelligence, improving resilience today while preparing facilities for future growth.
Ready to modernize your facility operations?
Learn more about Flagship Lab Services and how our lab support teams help protect research integrity, strengthen compliance, and keep operations running reliably.
Leave a Comment